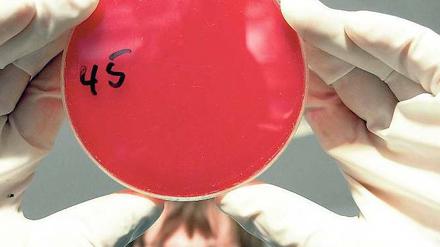

Die S&K-Gruppe steht für einen der größten Anlagebetrugsfälle der letzten Jahre. Mit einem Schneeballsystem sollen Manager zehntausende Anleger geschädigt haben. Welche Rolle spielten die Banken?

Die S&K-Gruppe steht für einen der größten Anlagebetrugsfälle der letzten Jahre. Mit einem Schneeballsystem sollen Manager zehntausende Anleger geschädigt haben. Welche Rolle spielten die Banken?
Die BR Volleys festigen mit dem 3:0 gegen Budva Platz zwei in der Champions League, stehen kurz vor dem Einzug in die zweite Runde - und hoffen weiter auf das Final-Four-Turnier.

Bildungssenatorin Sandra Scheeres genehmigt weitere gymnasiale Oberstufen. Die betroffenen Sekundarschulen hatten lange gekämpft. Andere müssen warten.
Überraschung aus Redmond: Microsoft stellt neben Windows 10 die Datenbrille HoloLens vor, mit der "Star Trek"-Fantasien Realität werden.

Überraschung aus Redmond: Microsoft stellt neben Windows 10 die Datenbrille HoloLens vor, mit der "Star Trek"-Fantasien Realität werden.

In Leipzig herrscht Ausnahmezustand wegen der Legida-Demonstration. Von den angepeilten 40.000 Teilnehmern ist die Anti-Islam-Bewegung aber noch weit entfernt. Pegida-Sprecherin Kathrin Oertel kündigte unterdessen rechtliche Schritte gegen den Legida an.

Lutz Bachmann gehört zu den Gründern der islamkritischen Pegida-Bewegung. Wegen rassistischer Kommentare geriet er in die Kritik. Nun hat er Konsequenzen gezogen.

Ein ungewöhnlicher Vorgang: Die "Eliteschule des Sports" revidiert ihren eigenen Beschluss zur Umbenennung. Der Name des Widerstandskämpfers bleibt. Und der Schulleiter sagt auch, warum.

Das ist neu: Der FC Bayern kann auch kleinlaut - nicht nur deswegen könnte das umstrittene Gastspiel der Münchner in Saudi-Arabien auch etwas Gutes gehabt haben. Ein Kommentar.

Im Jemen deutet sich eine Einigung im Konflikt zwischen Huthi-Rebellen und Präsident Abd Rabbo Mansur Hadi an. Am Dienstag hatte es blutige Kämpfe um den Präsidentenpalast in der Hauptstadt Sanaa gegeben.
Mit gezielten Erbgut-Eingriffen verhindern Forscher, dass gentechnisch erzeugte Organismen aus dem Labor türmen können. Denn sie brauchen Substanzen, die nicht in der Natur vorkommen.

Die ungeliebte Passage an der Joachimsthaler Straße wird ab Februar abgerissen, die letzten Mieter müssen ihre Läden räumen.

Der zuletzt abgeflaute Streit um den Maschendrahtzaun am Pfingstberg flammt wieder auf. CDU-Politiker wirft Oberbürgermeister "Unlauterkeit" auf, der weist die Vorwürfe aber zurück.

Pegida-Chef Lutz Bachmann ist zurückgetreten. Zuvor hatte die Staatsanwaltschaft Dresden förmliche Ermittlungen gegen ihn eingeleitet. Bei Facebook soll Bachmann Flüchtlinge in einem Kommentar als "Viehzeug" bezeichnet haben und es kursierten Bilder von ihm in Hitler-Verkleidung..

Gemeinsam mit dem österreichischen Bundeskanzler Werner Faymann verlangt EU-Parlamentschef Martin Schulz vom saudischen Kronprinzen die Freilassung des Bloggers Raif Badawi. Die Verurteilung zu 1000 Stockhieben widerspreche der Anti-Folter-Konvention der UN, erklären die beiden Politiker.

Die Dschungelcamper sind verkappte Terroristen: Walter will Gauck aus dem Amt jagen, Patricia Blanco bringt Senioren in die Gewalt ihres Silikon-Busens. Tag 5 in der Nachlese.

Rentner klagt gegen die chinesische Fluglinie Hainan auf Schadenersatz. Maschine soll ein Knalltrauma und verschiedene gesundheitliche Beschwerden ausgelöst haben. Einen Vergleich lehnte die Airline ab.

Premierminister Manuel Valls hat eine territoriale, soziale und ethnische Apartheid in Frankreich ausgemacht. Das kann etwas bewirken - und das gesellschaftliche Bewusstsein in Frankreich ändern. Ein Kommentar.
Die Düsseldorfer Designerin präsentiert ihre farbenfrohen Entwürfe in der Villa Elisabeth in Mitte
70 Jahre nach Kriegsende sind vier Gemälde wieder in Potsdam. Die Rückkehr der Bilder erfolgte sehr abenteuerlich. Viele Werke werden aber noch vermisst.

Zu eineinhalb Jahren auf Bewährung verurteilte das Amtsgericht Lübben einen 29-jährigen Erzieher. Er hatte mit einer 15-Jährigen geschlafen - aus Liebe, wie er beteuerte.

Das Gerücht kursierte schon eine Weile - jetzt ist es zur Gewissheit geworden: Die Großhalle am Ostbahnhof wird umbenannt. Die Namensrechte übernimmt Mercedes-Benz. Und das für eine lange Zeit.

Der Fall wird immer komplexer. Nun tauchen Informationen auf, die Sebastian Edathys Version stützen könnten. Nach Berichten soll er auch kinderpornografisches Material aus Russland bezogen haben.

In Tel Aviv sticht ein Palästinenser auf Passagiere eines Busses ein – die Behörden sprechen von Terror. Die Hamas verteidigt die Attacke als "Selbstverteidigung".

Teilt der Eigentümer einem Mieter nicht mit, dass seine Wohnung verkauft werden soll, kann das für ihn teuer werden. Denn Mietern, die deshalb ihr Vorkaufsrecht nicht geltend machen können, steht eine Entschädigung zu.
Die Arbeitsgemeinschaft City und die Stadtreinigung verlängern ihr „Pilotprojekt für eine saubere City West“, das am Kurfürstendamm und in der Tauentzienstraße mehr Reinigungseinsätze ermöglicht.

Der Anteil weiblicher Vorstände stagniert – in einer Unternehmensgruppe geht er sogar leicht zurück. Forscher warnen vor „männlichen Monokulturen“.

Erst abgesagt, nun doch geplant: Hanau zeigt eine Werkschau der Karikaturen von Achim Greser und Heribert Lenz.

Die Dschungelcamper sind verkappte Terroristen: Walter will Gauck aus dem Amt jagen, Patricia Blanco bringt Senioren in die Gewalt ihres Silikon-Busens. Tag 5 in der Nachlese.
Ein Verbrechen kann sich auch für die Populärkultur lohnen: Was Sie diese Woche im Radio nicht verpassen sollten.

„In aller Freundschaft – Die jungen Ärzte“ soll das ARD-Vorabendprogramm aus dem Koma holen. Doch eine Rebellion gegen die Altvorderen wird es nicht geben.

Monatelang suchte Repsol vor der Küste der Kanaren nach Bodenschätzen – begleitet von heftigen Protesten. Nun werden die Probebohrungen überraschend eingestellt. Aus Kostengründen, heißt es. Die Inselbewohner sprechen von einem "Sieg des Volkes".

Wird alles besser - und bleibt vieles beim Alten: Suhrkamp hat die Umwandlung in eine Aktiengesellschaft vollzogen und die Ströhers als Aktionäre ins Verlagsboot geholt. Verlegerin Ulla Unseld-Berkéwicz zieht sich aus dem operativen Geschäft zurück, Jonathan Landgrebe wird alleiniger Vorstand.
Am 24. Januar lädt das Heinz-Berggruen-Gymnasium interessierte Eltern und Schüler zu einem Tag der offenen Tür ein.

Elsterwerda/Ludwigsfelde - Ein 36-Jähriger ist in Südbrandenburg mit einem Messer auf Polizisten losgegangen und wurde dabei durch einen Schuss aus einer Dienstwaffe verletzt. Der Mann wurde in ein Krankenhaus gebracht, schwebt aber nicht in Lebensgefahr, wie die Staatsanwaltschaft Cottbus am Mittwoch mitteilte.

Nach den schweren Anschlägen in Paris verstärkt Frankreich seinen Anti-Terror-Kampf. Mehr Personal und mehr Überwachung soll zu mehr Sicherheit führen.

Die Kanzlerin empfängt Aserbaidschans Staatschef Ilham Alijew zum Mittagessen – und mahnt die Einhaltung der Menschenrechte an. Von Problemen in seinem Land will der Gast aber nichts wissen.

Schwer verletzt liegt eine 21-Jährige seit Mittwochmorgen im Krankenhaus. Sie war beim Überholen geschnitten worden und war in die Leitplanke gekracht.

Am 176. Tag wird weiter der Bombenanschlag in der Keupstraße in Köln verhandelt. 22 Menschen wurden damals verletzt, viele kämpfen bis heute mit den Folgen. Zeugen erzählen beklemmende Geschichten.
Das Spiel gegen Budvanska Rivijera Budva in der Champions League ist das bisher vielleicht wichtigste für die BR Volleys in dieser Saison. Deswegen treten die Berliner auch in Bestbesetzung an.

Berlin will seiner Olympia-Bewerbung jetzt Schwung verleihen. Senat und Betriebe werben um die Spiele – nicht nur im Fanartikelshop, sondern auch mit Sportleressen und absurden Plakaten.
Ein Verbrechen kann sich auch für die Populärkultur lohnen: Was Sie diese Woche im Radio nicht verpassen sollten.

„In aller Freundschaft – Die jungen Ärzte“ soll das ARD-Vorabendprogramm aus dem Koma holen. Doch eine Rebellion gegen die Altvorderen wird es nicht geben.
Österreich hat bei der Handball-Weltmeisterschaft in Katar vorzeitig das Achtelfinale erreicht.

Diesmal ging nichts schief. Lisa Zimmermann wird in Österreich Weltmeisterin im Slopestyle - und damit anders als bei Olympia 2014 ihrer Favoritenrolle gerecht.

Keinen Cent vom Staat für fünf Jahre: So günstig konnte sich die Bundesrepublik noch nie verschulden. Doch warum werden solch unattraktive Papiere gekauft?
Im Potsdamer Landtag äußerte sich Innenminister Schröter über die Ermittlungen gegen radikale Islamisten. Zu den Ergebnissen sagte er nichts. Dafür äußerte er sich zu der Sicherheitslage in Brandenburg.

Der Mercedes-Pilot zeigt sich gut gelaunt in Berlin. Das verlorene WM-Finale gegen Lewis Hamilton scheint er verarbeitet zu haben - Experten sehen ihn für das Duell in diesem Jahr sogar gestärkt.
öffnet in neuem Tab oder Fenster